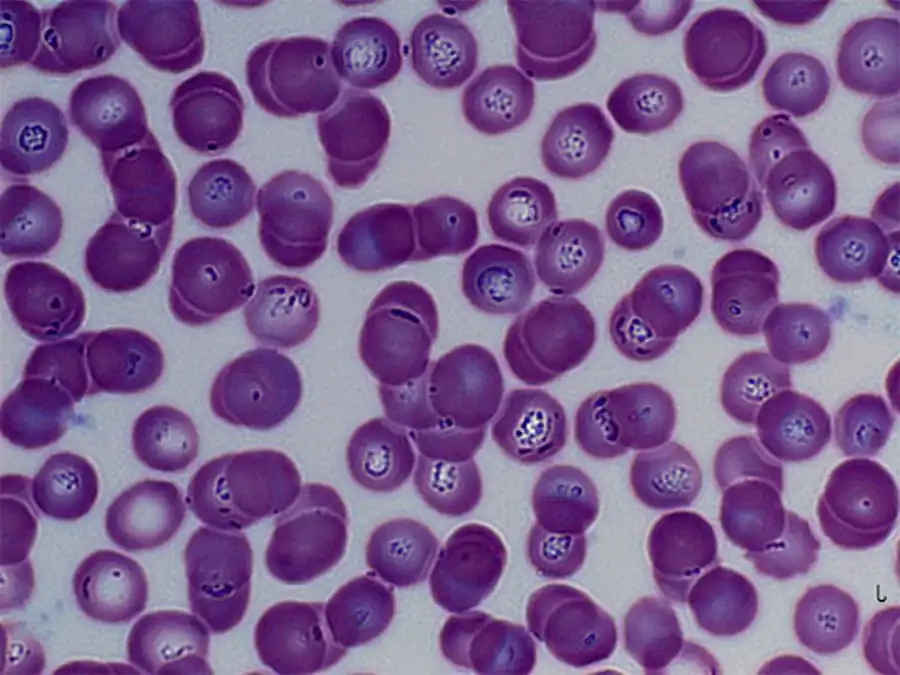

Множественное деление тейлериид
У тейлериид множественное деление происходит в организме крупного рогатого скота, главным образом в лимфатических узлах. Часть продуктов деления вновь проникает в клетки селезенки, другая часть попадает в эритроциты. Переносчиками тейлериид служат иксодовые клещи Ripicephalus, Hyalomma и др. По-видимому, в организме клещей происходит образование гамет, которые копулируют и образуют зиготы. В результате размножения в слюнных железах образуются спорозоиты, которые и служат источником заражения крупного рогатого скота.
Все представители бабезиид и тейлериид паразитируют в эритроцитах крупного рогатого скота, лошадей, свиней, собак и других млекопитающих и вызывают тяжелые заболевания, приносящие большой вред животноводству.
Babesia bigemina — возбудитель «техасской лихорадки» крупного рогатого скота. В СССР это заболевание распространено на Северном Кавказе, в Закавказье и Средней Азии. Заболевшие животные худеют, становятся малокровными, моча их окрашивается в красный или бурый цвет. На Кавказе переносчиком служит клещ Margaropus annulatus calcaratus. Nutallia equi паразитирует в эритроцитах лошади и является возбудителем опасного заболевания, часто кончающегося смертью животного; распространен в южных районах СССР. Переносчики — несколько видов клещей рода Ripicephalus. Piroplasma ovis — возбудитель пироплазмоза овец, Babesiella bovis вызывает тяжелый пироплазмоз коров, переносится обыкновенным собачьим клещом Ixodes ricinus.
Так как инфекцию переносят клещи, то профилактика пироплазмозов состоит в уничтожении клещей путем купания зараженных животных в дезинфицирующих жидкостях. Другим способом профилактики являются перегонка стад на свежие пастбища и уничтожение клещей на зараженных площадях, а также запрещение ввоза в благополучные районы больного пироплазмозом скота и т. п.